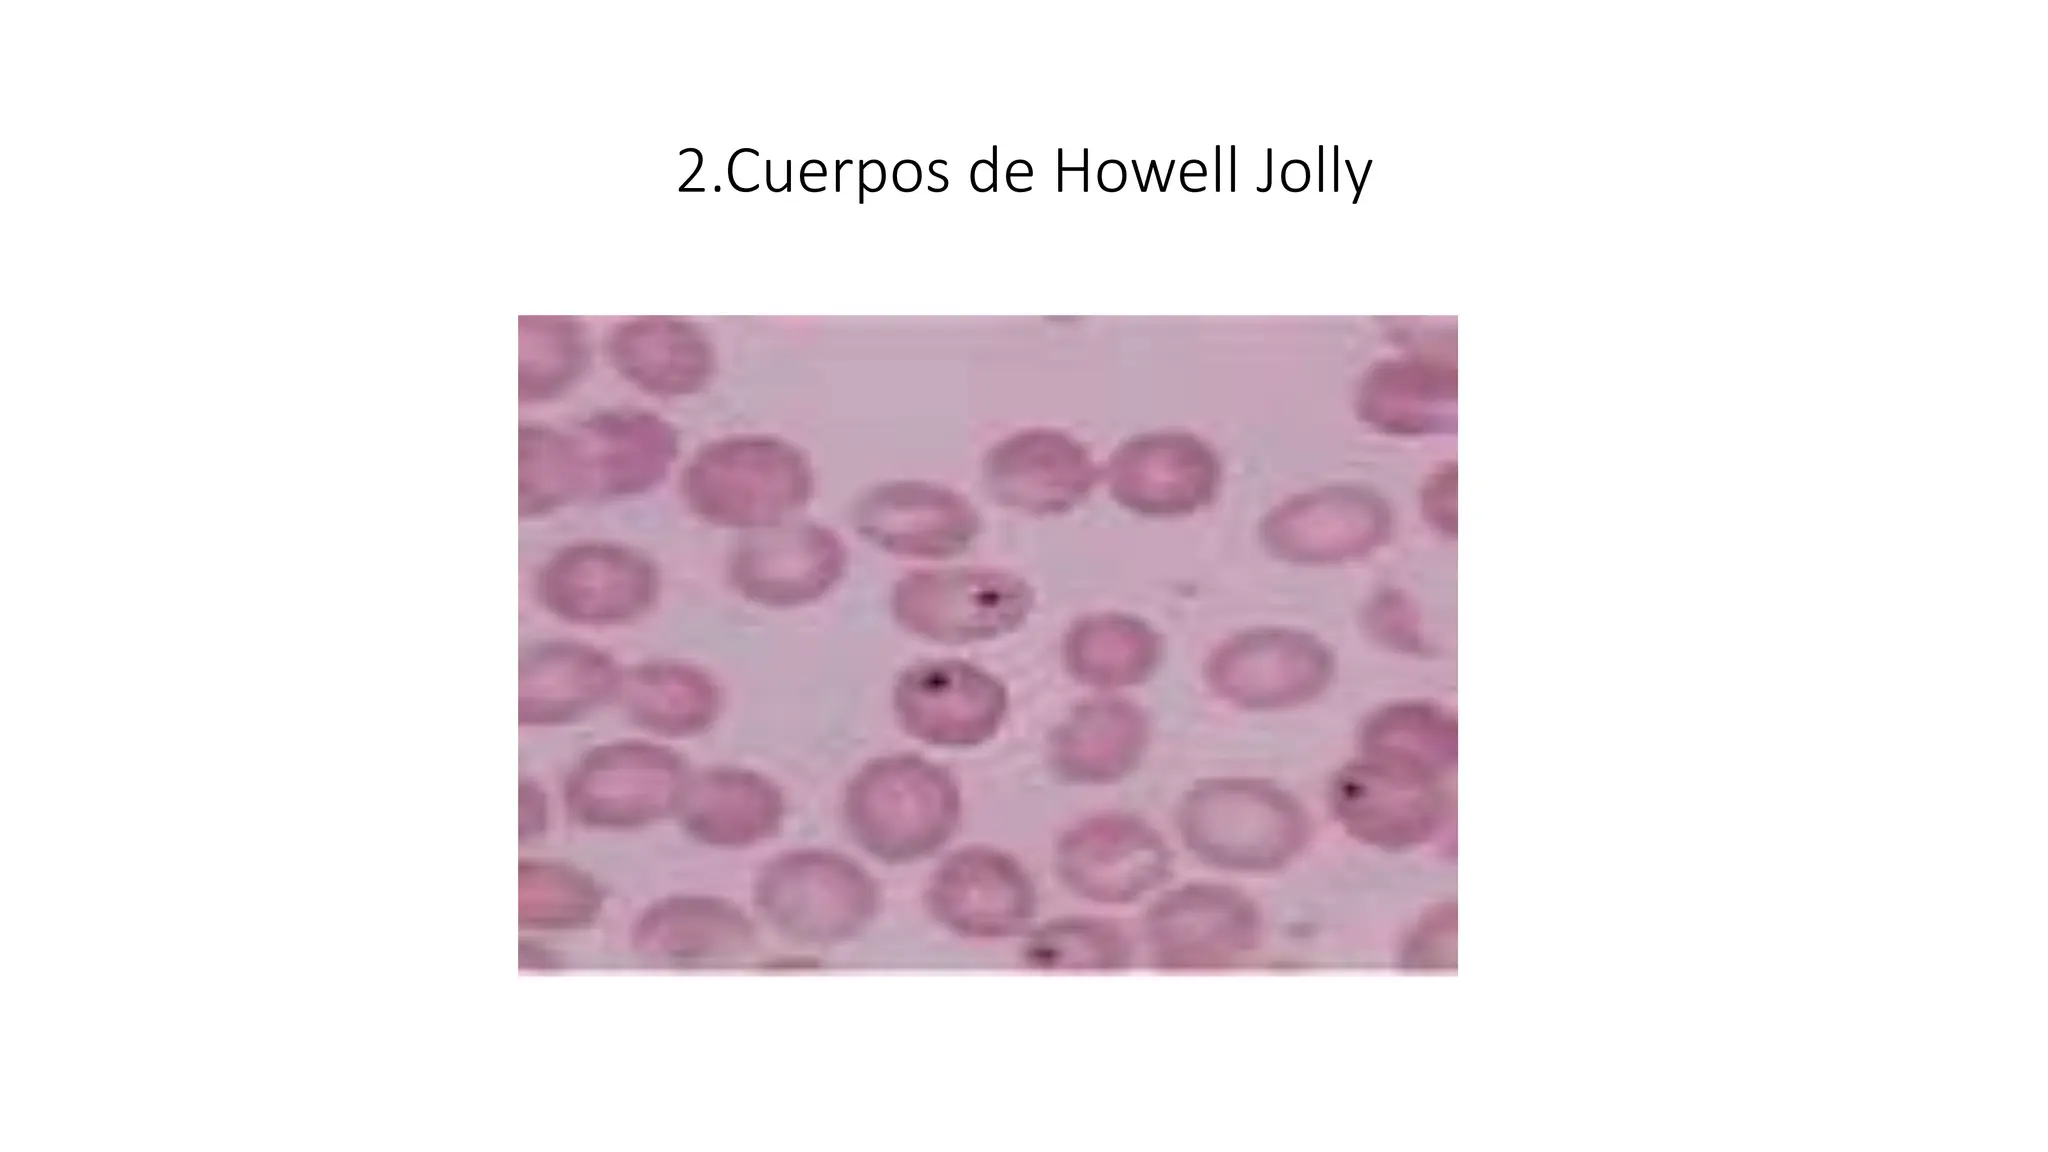
2.Cuerpos de Howell Jolly
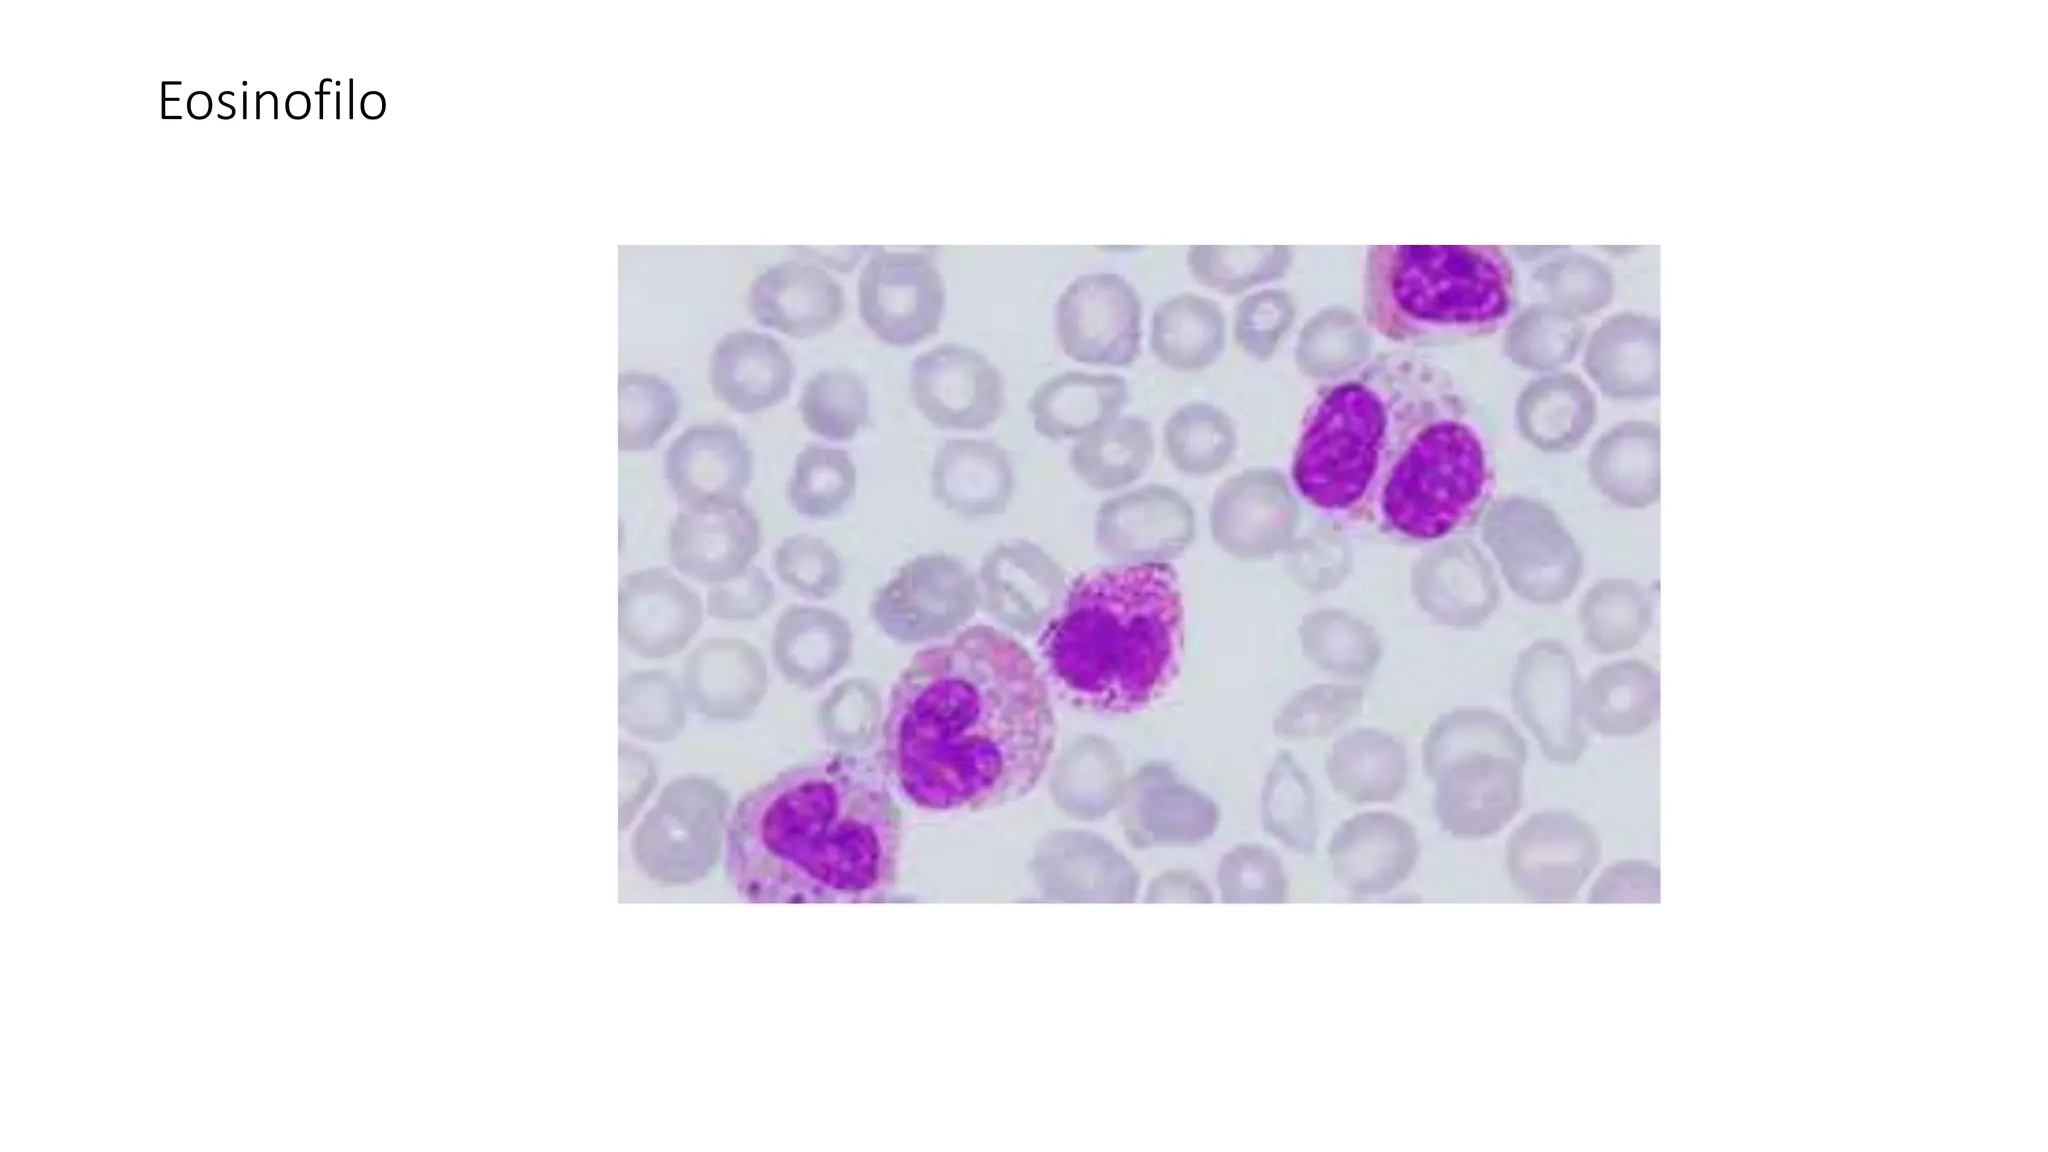
Eosinofilo

Los eritrocitos son células encargadas del transporte de oxígeno y dióxido de carbono, cuya formación se regula mediante la eritropoyetina. Su morfología y alteraciones son críticas para el diagnóstico de diversas enfermedades hematológicas, como anemias, que implican cambios en tamaño, forma y color. Los índices eritrocíticos permiten clasificar la anemia y determinar el tipo y la causa, siendo fundamental en el manejo clínico de afecciones en especies domésticas.